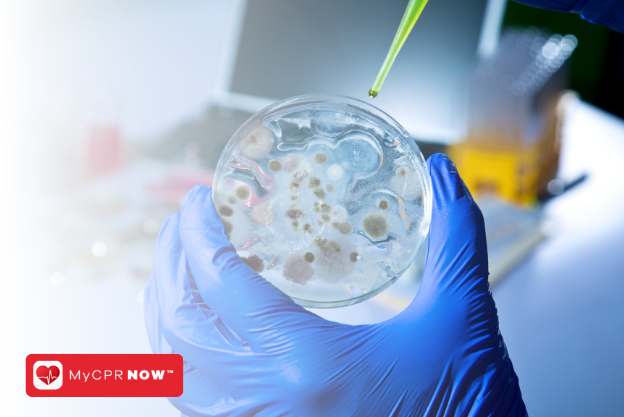

Bloodborne Pathogens Certification Renewal
Here are some of the images for Bloodborne Pathogens Certification Renewal that we found in our website database.

Bloodborne Pathogens Certification Renewal Process

OSHA Med Certs Check your calendar for your OSHA Bloodborne Pathogens

AEDCPR Catalog OSHA Bloodborne Pathogens Renewal Class

Bloodborne Pathogens (BBP) Practice Test Answers

Bloodborne Pathogens Recertification Online Renewal ACLS

Bloodborne Pathogens Certification online at $14 99

Bloodborne Pathogens Recertification Online Renewal ACLS

How Long Does a Bloodborne Pathogens Certification Last? Desk Surfing

Bloodborne Pathogens FAQ: Most Searched

When Is Bloodborne Pathogens Certification Necessary AED CPR

How Long Does Bloodborne Pathogens Certification Last? 8 Things to Know

Bloodborne Pathogens Training for Janitorial Staff

How Long Does Bloodborne Pathogens Certification Last? 8 Things to Know

Understanding a Bloodborne Pathogens Certification

Workplace Safety: Bloodborne Pathogens Certification

Bloodborne Pathogens Certification: An Overview

Bloodborne Pathogens Training for Firefighters and EMS

Bloodborne Pathogens Certification: The Ultimate Safety Measure MyCPR NOW

Why You Need A Bloodborne Pathogens Certification

Bloodborne Pathogens Certification for Health Workers

Bloodborne Pathogens Certification: Ensuring Safety at Work

Understanding Bloodborne Pathogens: The Need for Certification

Safety First: Understanding Bloodborne Pathogens Certification

Bloodborne Pathogens Exposure

A Guide to How to Get Bloodborne Pathogens Certification LearnTastic

A Guide to How to Get Bloodborne Pathogens Certification LearnTastic

Bloodborne Pathogens Certification: The Basics and Beyond

Bloodborne Pathogens Certification: A Prerequisite for Safety

Bloodborne Pathogens Training Online Course and Certification
The Real Importance of Bloodborne Pathogens Certification

Bloodborne Pathogens Certification: How It Protects You

AHA Bloodborne Pathogens Certification Classes

Why Bloodborne Pathogens Certification is Essential for Safety

Bloodborne Pathogens Certification: A Closer Look

Bloodborne Pathogens Certification: A Vital Tool in Medical Field

Online Bloodborne Pathogens Certification Tattoo Artist UK

Bloodborne Pathogens Certificate Bloodborne Pathogens Online Training

OSHA Bloodborne Pathogens Training Online Courses AED CPR

Lifeguarding Bloodborne Pathogens Training Certification PDF

Understanding the Most Prevalent Bloodborne Pathogens

How Many CEUs Can You Earn from ACLS Certification and Renewal?

What Are Bloodborne Pathogens? Understanding Risks

Important Things to Know About BLS Renewal

Bloodborne Pathogens Certification For Tattoo Artist California

Understanding Bloodborne Pathogens: A Comprehensive Guide to Safety and

OSHA Bloodborne Pathogens Certification Train Online

WPS Bloodborne Pathogens SafeCheck Learning

Free Bloodborne Pathogens Course Bloodborne Pathogens Certification

Checkout BBP Renew National OSHA Foundation

Basic Life Support (BLS) American Red Cross Same Day Certification

Bloodborne pathogens class certifications bloodborne pathogens online

OSHA Bloodborne Pathogens Training: Bleed the Way to Safety

Airborne And Bloodborne Pathogens Certification BLS Course

Guide to Becoming a Medical Courier: Mastering Bloodborne Pathogens and

Who Needs CPR Certification Training? AEDCPR

CPR Recertification and Renewal Options Online CPR Certification

Common risk of exposure to bloodborne pathogens for healthcare workers

Bloodborne Pathogens Training Materials

This renewal course usually has duration of four hours to finish This

Commercial Cleaning Services White Glove Cleaning Professionals